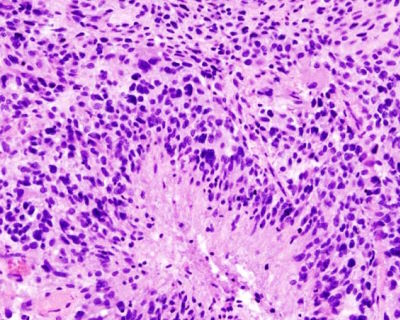

U přibližně každého čtvrtého druhu rakoviny dochází k chromotripsi, chaotickému rozpadu chromozomů, jež vyvolává vlnu genetických změn, které pomáhají nádorům odolávat terapii. Vědcům se nyní podařilo zjistit, co chromatotripsi spouští.
Věří, že by to mohl být další významný krok na cestě k poražení rakoviny..
Při chromatotripsi se chromozom rozdělí na mnoho fragmentů, které se následně spojí zpět v nesprávném pořadí. Toto chaotické přeskupení umožňuje rakovinným buňkám rychlý vývoj a rozvoj rezistence vůči léčbě.
Poprvé byla chropatotripse rozpoznána před více než deseti lety jako hlavní faktor v progresi rakoviny, vědci však dosud nevěděli, co je jejím skutečným spouštěčem. Až nyní se vědcům z Kalifornské univerzity v San Diegu podařilo identifikovat enzym, jež je za chromatotripsi zřejmě odpovědný.
Chromatotripsie zhoršuje agresivitu rakoviny
Rakovinné buňky používají k přežití terapie několik taktik, ale chromotripse vyniká svým obrovským rozsahem. Spíše než postupné hromadění mutací v průběhu času může tento proces vytvořit desítky nebo dokonce stovky genetických změn v jediné katastrofické epizodě.
Výsledkem je rychlý vývojový impulz, který může ztížit kontrolu nádorů. Navíc je chromatotripse překvapivě častá, přibližně jeden ze čtyř druhů rakoviny vykazuje známky tohoto typu poškození chromozomů.
U některých druhů rakoviny je tato míra dokonce ještě vyšší – téměř všechny osteosarkomy, agresivní rakovina kostí, vykazují výrazné známky chromatotripse, stejně jako mnoho druhů rakoviny mozku. „Tento objev konečně odhaluje molekulární ‚jiskru‘, která zažehává jednu z nejagresivnějších forem přeskupení genomu u rakoviny,“ říká hlavní autor studie Don Cleveland, profesor buněčné a molekulární medicíny na Lékařské fakultě UC San Diego.
„Zjištěním, co v první řadě narušuje chromozom, nyní máme nový a akční bod pro zpomalení vývoje rakoviny,“ dodává.
Chromozomální chaos spouští N4BP2
Při chromatotripsi uvězní chyby během buněčného dělení chromozomy uvnitř malých, křehkých kompartmentů zvaných mikrojádra. Když mikrojádro praskne, chromozom uvnitř zůstane obnažený. V tom okamžiku se stává zranitelným vůči nukleázám neboli enzymům, které mohou štěpit řetězce DNA. Vědci až doposud nevěděli, která nukleáza je odpovědná za spuštění této destruktivní řetězové reakce, což ztěžovalo možnost navržení účinné terapie k jejímu zastavení.
Aby tým z UCSD přesně určil příčinu, použil zobrazovací screeningový přístup k systematickému zkoumání všech známých a předpokládaných lidských nukleáz. Vědci sledovali, jak se každý enzym chová v živých rakovinných buňkách.
Jeden enzym, N4BP2, nad ostatními vynikal. Byl jedinečně schopen proniknout do mikrojader a fragmentovat DNA uvnitř. Když jej vědci odstranili z buněk rakoviny mozku, rozpad chromozomů dramaticky poklesl, oproti tomu, když N4BP2 naopak vnutili do buněčného jádra, intaktní chromozomy se začaly rozpadat, a to i ve zdravých buňkách.
Naděje na zpomalení rakoviny
„Tyto experimenty nám ukázaly, že N4BP2 nekoreluje pouze s chromotripsií. Je však dostatečný k jejímu vyvolání,“ uvádí Ksenia Krupinová, která se na studii podílela. „Toto je první přímé molekulární vysvětlení toho, jak začíná katastrofická fragmentace chromozomů,“ doplňuje.
Vědci rovněž zkoumali i více než 10 000 rakovinných genomů zahrnujících různé typy nádorů. Ty s vyššími hladinami N4BP2 nejenže vykazovaly více chromatotripsie, ale měly i zvýšené množství extrachromozomální DNA (ecDNA), kruhových fragmentů DNA, které často nesou geny podporující rakovinu a jsou úzce spojeny s agresivním růstem a rezistencí na terapii.
Nové poznatky naznačují, že ecDNA není samostatným jevem, ale spíše následkem chromotripsie. Umístěním N4BP2 na samý začátek tohoto procesu studie zdůrazňuje klíčový vstupní bod pro pochopení a potenciální kontrolu některých z nejnebezpečnějších forem nestability genomu rakoviny.
„Pochopení toho, co spouští chromotripsii, nám dává nový způsob, jak přemýšlet o jejím zastavení,“ doufá Cleveland a dodává: „Zaměřením se na N4BP2 nebo dráhy, které aktivuje, bychom mohli být schopni omezit genomický chaos, který umožňuje nádorům adaptovat se, recidivovat a stát se rezistentními vůči lékům.“.
Zdroje: ScienceDaily